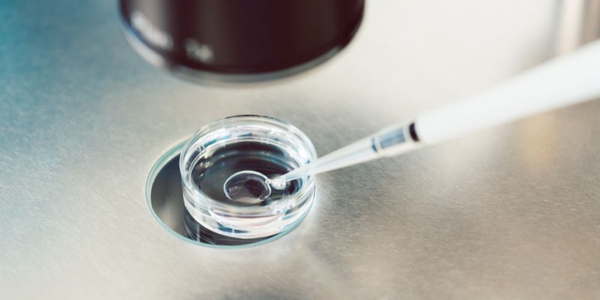
Optimized timing for egg retrieval in Navi Mumbai at Sattva Fertility Care Center

What is Ovulation Induction?
Ovulation induction in IVF (In Vitro Fertilization) is a medical procedure aimed at stimulating the ovaries to produce multiple eggs for retrieval and fertilization outside the body.
Discover effective Ovulation Induction Service with Dr. Priya Khamatkar in Navi Mumbai at Sattva Fertility Care Center. Boost your chances of pregnancy. Schedule your consultation today!